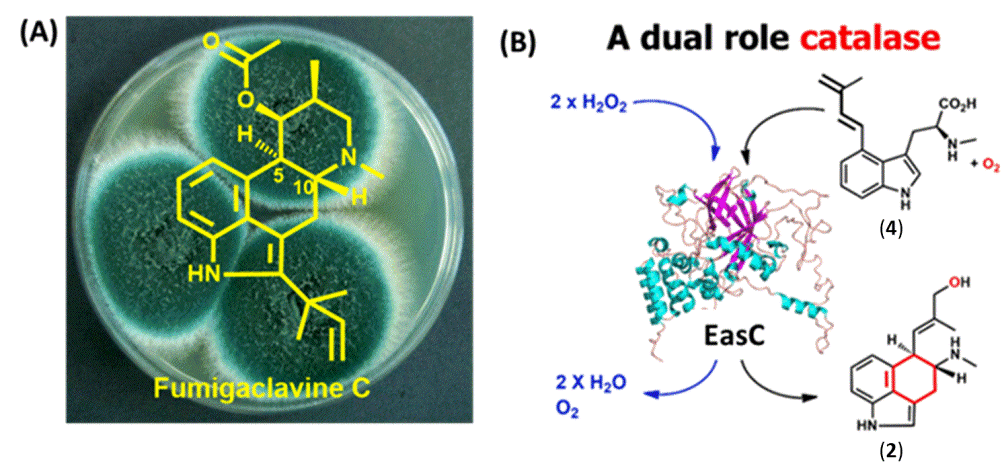

麦角生物碱类化合物最早于上世纪从真菌中分离得到,并广泛产生于多种曲霉和青霉,被誉为最重要的临床药用分子和天然毒素(图1A),在欧美市场上被广泛用来治疗癌症、偏头疼、产后大出血和帕金森症,FDA批准的上市药物有12种。研究表明,麦角生物碱结构中的Ergoline四元环是该类化合物的药效团,它与神经递质的结构比较类似,可以特异性结合人脑中的各种神经递质受体。自20世纪50年代以来,药效团Ergoline环中的C环生物合成机制一直是各国科学家的研究重点,在该领域发表了大量论文,前辈科学家的研究证明了EasC和EasE两个蛋白参与了C环的生物合成(图1B),但是具体的分子生物学与酶学机制仍然没有解析清楚。

图1:(A)麦角生物碱类药物;(B)中心碳环形成
烟曲霉(Aspergillus fumigatus)可以产生麦角生物碱fumigaclavine C(图2A),并且其生物合成基因簇已经被报道。麦角生物碱化合物以色氨酸为起始,在途径合成的第一步酶(异戊烯基转移酶DmaW)和第二步酶(甲基转移酶EasF)催化下合成1。酵母和构巢曲霉中异源表达前四个基因(dmaW、easF、easE和easC),可以得到化合物2。但是体外从1到2是如何转化的却未见报道。本文研究者就这一悬而未决的科学问题展开了研究。
生物信息学分析EasE是一个FAD依赖的氧化酶,研究者推测其为下一步的催化酶,于是在构巢曲霉中共表达dmaW,easF和easE三个基因,产生了一个新化合物4(图2B)。将4喂养烟曲霉ΔdmaW菌株,则修复了3的产生,证明4是途径中的中间体。同源蛋白序列比对发现,EasC与过氧化氢酶(catalase)中的小亚基家族(SSC)高度同源,但是又具有多个不同的保守氨基酸位点。聚类分析发现,EasC蛋白处于一个独立的分支。这些结果都表明EasC可能不仅仅具有过氧化氢酶活性。此外蛋白同源建模发现,该蛋白含有与SSC类似的heme和NADPH结合位点。因此研究者推测EasC在化合物2的合成中具有重要功能。于是,研究者将easC,dmaW,easF和easE基因共同表达于构巢曲霉中,HPLC分析发现产生了新化合物,NMR结构鉴定该化合物的确是化合物2。接着,研究者在大肠杆菌中纯化得到了可溶性的EasC蛋白,EasC可以在体外分解过氧化氢,验证了其过氧化酶活性。由于研究报道的过氧化氢酶和过氧化物酶均利用过氧化氢作为氧化剂,催化氧化还原反应的进行。但是研究者利用各种生化反应手段,包括反应体系添加或不添加过氧化氢、无氧催化、有氧催化、同位素标记(18O2和H218O)等,在体外发现EasC蛋白是利用氧气作为氧化剂,而不是过氧化氢,区域和对映体选择性催化两个非活化的sp3 碳形成C-C键,并推测了EasC的催化机制,完整地解析了临床重要药物前体四环麦角生物碱的中心碳环形成机制。
图2:EasC是一种全新类型的双功能酶
本篇文章报道的过氧化氢酶EasC代表了一种全新类型的生物催化剂,它是自然界首个同时具有过氧化氢酶和单加氧酶活性的蛋白(图2B)。本项目解决了该类药物研究中半个多世纪以来悬而未决的难题,将为该类药物的工业菌株优化、代谢工程改造等研究打下坚实基础。该研究成果已在Journal of the American Chemical Society(JACS)杂志在线发表,题为“A Catalase Involved in Oxidative Cyclization of the Tetracyclic Ergoline of Fungal Ergot Alkaloids”。中科院微生物研究所助理研究员姚永鹏博士和博士后安春艳博士为论文共同第一作者,中科院微生物研究所高书山研究员和加州大学洛杉矶分校K. N. Houk教授为共同通讯作者。该工作受到科技部重点研发计划、中科院先导专项、自然科学基金委面上和青年项目以及中国科学院青年促进会会员项目的经费支持。
附件下载: